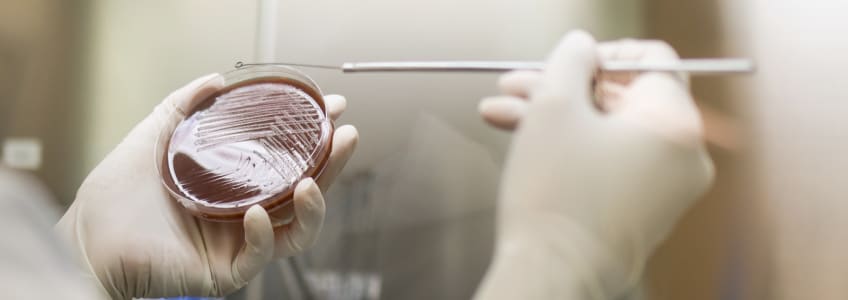
análise laboratorial de bactéria

Gonorreia: o que é e quais são os perigos desta IST
• 4 mins. leitura
Índice
- 1. Causas
- 2. Sintomas
- 3. Prevenção
- 4. Tratamento
- 5. Prognóstico
A Organização Mundial da Saúde estima que, em 2020, tenham ocorrido 82,4 milhões de novas infeções de gonorreia, entre adultos em todo o mundo. Estes números fazem desta a segunda infeção sexualmente transmissível (IST) mais comum causada por bactérias, logo a seguir à clamídia.
A incidência é semelhante em homens e mulheres jovens sexualmente ativas e algumas estatísticas mostram uma prevalência comparável em mulheres dos 15 aos 24 anos.
Causas
O agente causador da gonorreia é uma bactéria chamada Neisseria gonorrhoeae, transmitida principalmente por contacto sexual vaginal, oral ou anal.
Outras formas de transmissão da gonorreia também podem incluir:
Contacto próximo entre os genitais sem envolver penetração;
Partilha de brinquedos sexuais que não foram higienizados ou protegidos com preservativo;
Parto vaginal, ou seja, mulheres com esta IST podem transmiti-la ao bebé. Para prevenir a oftalmia neonatal, é realizada a profilaxia ocular, que consiste na aplicação de uma pomada de eritromicina nos olhos do recém-nascido. No entanto, se o bebé nascer por cesariana, não é possível desenvolver a infeção da mãe.
A gonorreia é contagiosa, mas nem todos os atos íntimos ou troca de fluidos corporais colocam a pessoa em risco de a desenvolver.
Não é possível ficar infetado com esta IST ao beijar, abraçar, dar as mãos, usar a casa de banho após a pessoa infetada a utilizar e partilhar comida, bebida ou talheres.
Fatores de risco
Mulheres sexualmente ativas com menos de 25 anos e homens que têm relações sexuais com pessoas do mesmo sexo correm um maior risco de desenvolver esta IST.
Existem outros fatores que podem aumentar este risco, tais como:
Novo parceiro sexual;
Múltiplos parceiros sexuais;
Parceiro sexual que já teve relações sexuais com outras pessoas;
Não usar preservativo ou outras barreiras nas relações sexuais;
Histórico de gonorreia ou de outra IST;
Profissionais do sexo;
População prisional.

Sintomas
Nem todas as pessoas apresentam sintomas.
Quando ocorrem sinais e sintomas, geralmente manifestam-se cerca de 2 semanas após a infeção. Em alguns casos, podem surgir muitos meses depois.
O trato genital da mulher e do homem é a principal zona afetada, mas também podem aparecer sintomas em outras partes do corpo, como reto, olhos, garganta e articulações.
Gonorreia feminina
Os sintomas da infeção na mulher podem incluir:
Dor ao urinar;
Dor pélvica ou abdominal;
Aumento do corrimento vaginal;
Cervicite (sangramento pós-coito);
Secreção vaginal amarelada ou esverdeada;
Hemorragia vaginal entre os períodos menstruais, bem como após as relações sexuais.
Gonorreia masculina
Já os sintomas da gonorreia no homem podem englobar:
Dor ao urinar;
Secreção na ponta do pénis;
Dor ou inchaço num testículo.
Prevenção
A única maneira de evitar completamente uma IST é não ter relações sexuais vaginais, anais ou orais.
Para pessoas sexualmente ativas, há estratégias que podem ser adotadas para reduzir o risco de infeção, nomeadamente:
Usar preservativos ou protetores orais durante a relação sexual oral;
Usar um método de proteção de barreira, como preservativos, durante qualquer relação sexual vaginal ou anal;
Ter relações sexuais apenas com um parceiro monogâmico que não tenha a infeção.
No que diz respeito às grávidas, uma vez que o agente causador da gonorreia pode ser transmitido ao bebé durante o parto, é recomendável consultar o médico para realizar exames ginecológicos e, se necessário, efetuar o tratamento adequado.
Quanto mais rápido for feito o tratamento para a gonorreia, mais reduzidas são as possibilidades de a infeção causar problemas de saúde graves ao bebé.
Tratamento
Esta IST não desaparece sozinha. O tratamento da gonorreia é efetuado com antibióticos, que, na maioria dos casos, eliminam a infeção com sucesso.
Geralmente, a infeção desaparece até 1 semana após o início da toma do antibiótico. No entanto, é importante considerar que o tratamento não consegue:
Proteger de futuras infeções;
Reverter os danos causados pela infeção antes do início do tratamento.
Embora sejam transmitidas da mesma forma e apresentem sintomas semelhantes, a clamídia e a gonorreia são causadas por bactérias diferentes, pelo que cada uma destas IST requer tratamento com um antibiótico específico.

Complicações
A gonorreia não tratada pode levar a graves complicações, incluindo:
Infeção de outras partes do corpo: a bactéria Neisseria gonorrhoeae pode espalhar-se pela corrente sanguínea e afetar outras partes do corpo, incluindo as articulações, provocando problemas como artrite, tenossinovite ou lesões dermatológicas;
Aumento do risco de VIH/SIDA: a IST deixa uma pessoa mais suscetível à infeção pelo VIH, o vírus que causa a SIDA;
Complicações em bebés: bebés com a infeção transmitida pela mãe durante o parto vaginal podem desenvolver infeções, cegueira e feridas no couro cabeludo;
Infertilidade em mulheres: a IST pode espalhar-se para o útero e trompas de Falópio, causando doença inflamatória pélvica (DIP);
Infertilidade em homens: a gonorreia no homem pode causar inflamação no epidídimo, causando uma epididimite, que, sem tratamento, pode levar à infertilidade. Adicionalmente, pode causar cicatrizes na uretra, inflamação nos testículos e dor e inflamação na próstata.
Além disso, o desenvolvimento da resistência antimicrobiana por Neisseria gonorrhoeae é uma complicação com implicações sociais, correspondendo ao uso local, regional e nacional de antibióticos.
Prognóstico
Devido à progressão da resistência antimicrobiana, a morbidade por gonorreia aumentou nas últimas décadas.
No entanto, as pessoas que recebem tratamento imediato e seguem as instruções médicas podem regressar à rotina em uma ou em duas semanas. Com tratamento adequado, a cura ocorre em mais de 95% dos casos.
Uma vez que uma pessoa pode voltar a ser infetada, é essencial adotar medidas para evitar desenvolver a infeção e transmiti-la novamente, de modo a prevenir potenciais complicações de saúde.
É fundamental efetuar exames regulares de IST, bem como praticar sexo seguro, usar sempre preservativo e ser transparente com o parceiro sobre o seu histórico sexual.


